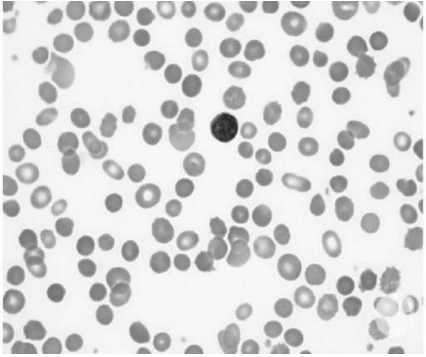
enunciado 1627540-1

Uma paciente de 16 anos de idade é encaminhada para avaliação por apresentar anemia. Ela queixa-se de fadiga recorrente, porém os sintomas pioraram no último ano. Não faz uso de medicamentos contínuos; utiliza somente polivitamínicos. No respectivo histórico familiar, não possui quadro de anemia crônica. Informa que a irmã mais velha foi submetida a colecistectomia aos 21 anos de idade. Ao exame físico, apresenta icterícia discreta e baço palpável a 3 cm do rebordo costal esquerdo. Os exames laboratoriais mostram hemoglobina = 9.1g/dL, leucócitos = 5.600 x 109 /L, plaquetas = 188.000 x 109 /L, VCM = 106 fL, reticulócitos = 8%, bilirrubina total = 2.8 mg/dL, direta = 0.5mg/dL e desidrogenase lática = 830 UI/mL. O esfregaço sanguíneo pode ser verificado a seguir.
Disponível em:<https://imagebank.hematology.org/atlas/60308> . Acesso em: 8 jan. 2021.
Considerando esse caso clínico, a imagem apresentada e os conhecimentos médicos correlatos, julgue os itens a seguir.
Em caso de crises de hemólise recorrentes, uma opção de tratamento é a realização de esplenectomia.